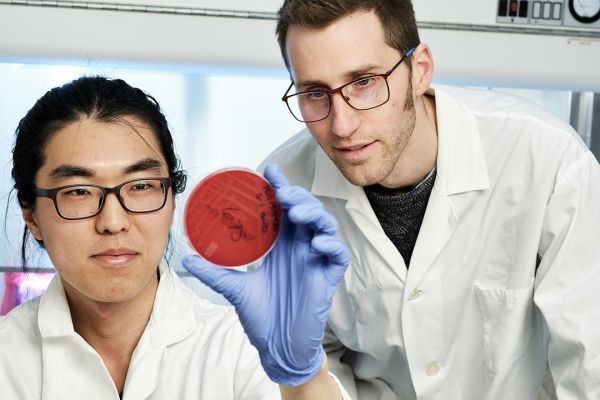

A University of Saskatchewan research team has found that some food imported to Saskatoon from certain Asian countries has tested positive for “superbugs”—strains of antibiotic-resistant bacteria— but immediate health concerns are likely low.
“Our study is among the first in Canada to look at antimicrobial resistance in imported plant-based products, and we hope our research will help expand the monitoring of antimicrobial resistance transmission to these foods which are currently not included in the national surveillance programs,” said Dr. Joe Rubin, USask veterinary microbiology professor.
Rubin and his recently graduated master’s student Dongyun Jung have analyzed almost 150 samples of spices, frozen vegetables and dry food including beans and seeds purchased in small shops which sell imported food.
The researchers found “superbugs” in eight samples—about five per cent of the products tested: E. coli; Klebsiella pneumoniae (a type of bacteria causing pneumonia); some species of Enterobacter and Enterococcus; Staphylococcus aureus and MRSA (Methicillin-resistantStaphylococcus aureus). All of these are versions of the bacteria resistant to antibiotics, and resistance may cause treatment failure or make infections more difficult to treat.
Continue reading at University of Saskatchewan.
Image via Dave Stobbe.